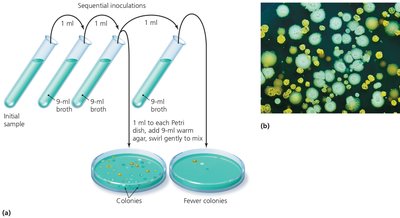
Pour plate method for isolating pure cultures
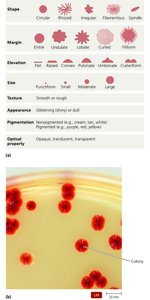
Colony morphology: shapes, margins, elevations, and appearance

BackMicrobial Nutrition and Growth: Study Notes
Study Guide - Smart Notes
Tailored notes based on your materials, expanded with key definitions, examples, and context.
Microbial Nutrition and Growth
Introduction to Microbial Growth
Microbial growth refers to an increase in the number of cells, not the size of individual cells. Microorganisms require a variety of nutrients to support their energy needs and to synthesize organic molecules and cellular structures. The most common elements required include carbon, oxygen, nitrogen, and hydrogen, which are obtained from diverse sources in the environment.
Essential Nutritional Requirements
Carbon Source: Microbes are classified based on their carbon source as autotrophs (using CO2) or heterotrophs (using organic compounds).
Energy Source: Organisms are further classified as phototrophs (using light) or chemotrophs (using chemical compounds).
Electron or Hydrogen Source: Required for redox reactions in metabolism.

Oxygen Requirements
Microorganisms differ in their oxygen requirements, which can be classified as follows:
Obligate aerobes: Require oxygen for growth.
Obligate anaerobes: Oxygen is toxic to these organisms.
Facultative anaerobes: Can grow with or without oxygen but grow better with it.
Aerotolerant anaerobes: Do not use oxygen but can tolerate its presence.
Microaerophiles: Require low levels of oxygen.

Chemical Requirements for Growth
Nitrogen: Essential for amino acids and nucleic acids.
Phosphorus: Important for nucleic acids, phospholipids, and ATP.
Sulfur: Found in some amino acids and vitamins.
Trace Elements: Required in small amounts (e.g., iron, copper, zinc).
Growth Factors: Organic compounds that some organisms cannot synthesize (e.g., amino acids, purines, pyrimidines, cholesterol, heme, NADH).
Growth Factor | Function |
|---|---|
Amino acids | Components of proteins |
Cholesterol | Used by mycoplasmas for cell membranes |
Heme | Functional portion of cytochromes in electron transport |
NADH | Electron carrier |
Niacin (vitamin B3) | Precursor of NAD+ and NADP+ |
Para-aminobenzoic acid (PABA) | Precursor of folic acid, involved in nucleic acid synthesis |
Physical Requirements for Growth
Temperature: Affects enzyme activity and membrane fluidity. Microbes are classified by their temperature preferences:

pH: Microbes are classified as neutrophiles (neutral pH), acidophiles (acidic pH), or alkalinophiles (alkaline pH).
Water: Essential for metabolic reactions; affects osmotic and hydrostatic pressure.
Osmolarity: Influences water movement across membranes (osmosis).
Pressure: Barophiles require high pressure for growth.

Culturing Microbes
Culturing involves growing microbes in controlled environments. A culture is the act of cultivating microbes or the collection of microbes grown. An inoculum is a sample introduced into a nutrient medium. Media can be liquid (broth) or solid (agar). Inocula are obtained from environmental, clinical, or stored specimens.
Specimen Collection Methods
Type/Location of Specimen | Collection Method |
|---|---|
Skin, accessible membranes, open wounds | Sterile swab brushed across surface |
Blood | Needle aspiration from vein; anticoagulants included |
Cerebrospinal fluid | Needle aspiration from subarachnoid space |
Stomach | Intubation via tube |
Urine | Catheterization or midstream clean catch |
Lungs | Sputum collection or catheterization |
Diseased tissue | Surgical removal (biopsy) |
Obtaining Pure Cultures
The goal is to isolate a pure culture from a single progenitor cell, known as a colony forming unit (CFU). Two common isolation techniques are:
Streak Plate Method: Involves spreading a diluted microbial sample over the surface of an agar plate to obtain isolated colonies.
Pour Plate Method: Involves serial dilution of a sample followed by mixing with molten agar and pouring into Petri dishes.
Colony Morphology
Colonies can be described by their shape, margin, elevation, size, texture, appearance, pigmentation, and optical properties. These characteristics help in identifying and classifying microbes.
Review Questions and Key Concepts
Obligate aerobes require oxygen for growth.
Obligate anaerobes are killed by oxygen and grow only in its absence.
The optimal growth temperature is where an organism exhibits its highest growth rate.
Photoheterotrophs use organic compounds as their carbon source, not carbon dioxide.